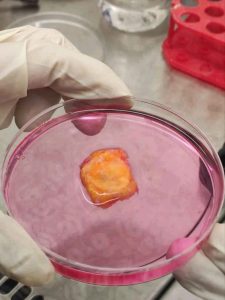

أعلن مركز أبوظبي للخلايا الجذعية (ADSCC) عن تحقيق إنجاز طبي جديد في مجال علاج السرطان، بعد نجاحه للمرة الأولى في عزل الخلايا اللمفاوية المتسللة إلى الأورام (TILs) من عينات مصابة بسرطانَي الثدي والرئة، تمهيدًا لإطلاق أول برنامج علاجي من هذا النوع في دولة الإمارات والعالم العربي.
ويُعدّ هذا التقدم خطوة محورية نحو اعتماد العلاج المناعي الشخصي، الذي يعتمد على خلايا المريض نفسه في مكافحة الخلايا السرطانية بدقة، ضمن دراسة رصدية مرخّصة من دائرة الصحة – أبوظبي.

ويقوم العلاج، حسب المركز، على استخراج الخلايا المناعية من الورم، ثم مضاعفتها في مختبرات متقدمة وفق معايير تصنيع عالية، قبل إعادتها إلى جسم المريض لاستهداف الخلايا السرطانية بفعالية أكبر مقارنة بالعلاجات الكيميائية التقليدية.
وأكدت الدكتورة زيمة موزورا هريرا، العالمة الرئيسية في المشروع، أنّ هذا العلاج: «يحوّل ورم المريض نفسه إلى جيش شخصي لمحاربة السرطان»، مشيرةً إلى أن الخلايا المعالجة «مدرّبة بطبيعتها على التعرف إلى الورم»، وأن دور الفريق الطبي «يتمثل بتطويرها واعادتها إلى الجسم لتأدية وظيفتها».

ويُظهر هذا الأسلوب نتائج واعدة في علاج الميلانوما، كما بدأ يُستخدم في أورام أخرى مثل سرطان الرئة وعنق الرحم والرأس والعنق، ويمثّل أملًا جديدًا للمرضى الذين استنفدوا خياراتهم العلاجية.
وقال البروفيسور يندري فينتورا، الرئيس التنفيذي لمركز أبوظبي للخلايا الجذعية، إن البرنامج الجديد «يشكل نموذجًا علاجيًا مختلفًا بالكامل، يسهم في توفير أحدث العلاجات المتقدمة داخل الدولة»، لافتًا إلى أنه «يتقاطع مع رؤية الإمارات في تعزيز الابتكار الطبي والتميز في الرعاية الصحية».
ويأتي هذا الإعلان بالتزامن مع احتفالات اليوم الوطني في الإمارات، بما يعكس التزام المركز بتطوير علاجات رائدة إقليميًا وعالميًا دون حاجة المرضى للسفر إلى الخارج.
كما يستعد المركز لتوسيع نطاق التجارب السريرية من خلال تطوير القدرة الصناعية لإنتاج خلايا TILs وخلايا TCR المعدّلة، بما يعزز مكانته كمركز متقدم للطب الحيوي في المنطقة.
وتأسس المركز عام 2018 لتقديم علاجات متخصصة بالخلايا الجذعية والطب التجديدي، ويضم برنامج أبوظبي لزراعة النخاع العظمي (AD-BMT©)، المعتمد كمركز تميّز من دائرة الصحة – أبوظبي. ويُعتبر أول وأبرز مركز لزراعة الخلايا الجذعية في الدولة، مع اعتماد مؤسسة FACT للعلاجات الخلوية، إضافة إلى بنية متطورة تشمل مختبرات تصنيع GMP ووحدات للاستشفاء والعلاج المناعي وتجميع الخلايا.


